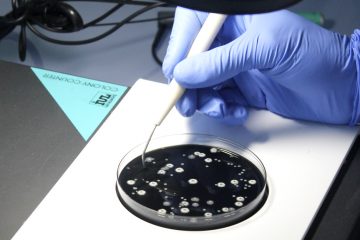
Ensayo laboratorio Inteman

Productos Químicos y Biotecnológicos para mantenimiento industrial
INTEMAN LaboratoriosInnovación
Ensayo Laboratorios
En nuestros laboratorios contamos con un equipo técnico de última generación y profesionales con una gran experiencia en el sector de los hidrocarburos, con capacidad para ofrecerte el mejor servicio personalizado para tu negocio.
Equipo Técnico
Nuestro equipo comercial así como químicos y biólogos están a tus disposición para obtener las mejores soluciones para ti y tu negocio. Estamos para lo que necesites.
Nuevos productos
Gestión y desarrollo de biocidas y aditivos de cara a mejorar la rentabilidad de los hidrocarburos y cuidado de los vehículos.

